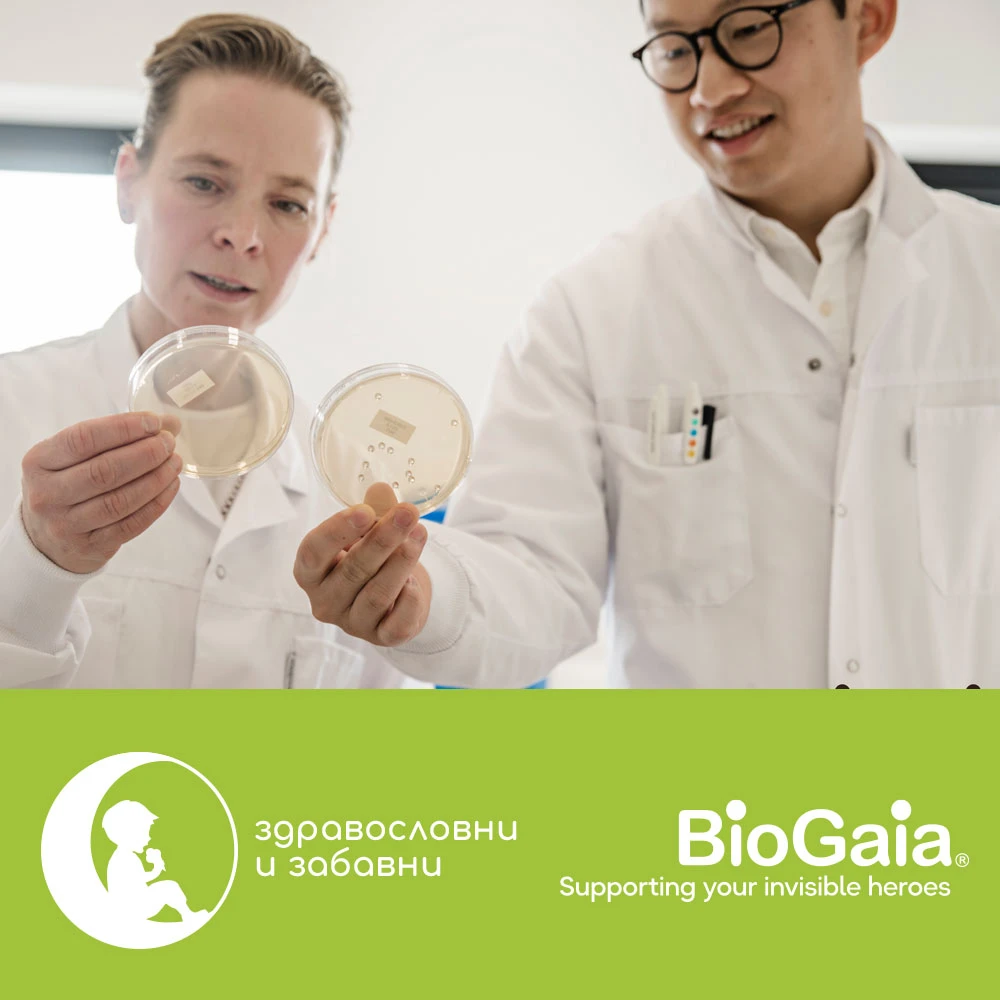
Пробиотици BioGaia® в подкрепа на „невидимите“ ни герои

BioGaia е шведска компания, която е един от световните лидерите в производството на пробиотици. Нашата цел е да помагаме на хората да живеят здравословно. BioGaia вече повече от 15 години има представителство в България.
Това, което ни отличава от всички е нашето желание за развитие на науката за микробиома и клиничните данни, които подкрепят ефективността и безопасността на нашите продукти. Пробиотици BioGaia® повлияват различни стомашно-чревни състояния и едновременно подобрява функцията на имунната система, а това допринася за по-доброто общо здраве. Разполагаме с удобна форма за всеки член на семейството (капки, дъвчащи таблетки, капсули), за да осигурим добро чревно здраве на цялото семейство!
Посетете щанда на BioGaia, за да научите повече за „невидимите“ герои в нашите коремчета.

BGA-advert-little-dreamers-event-EWO-BG-01439